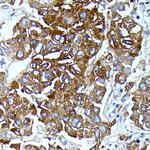
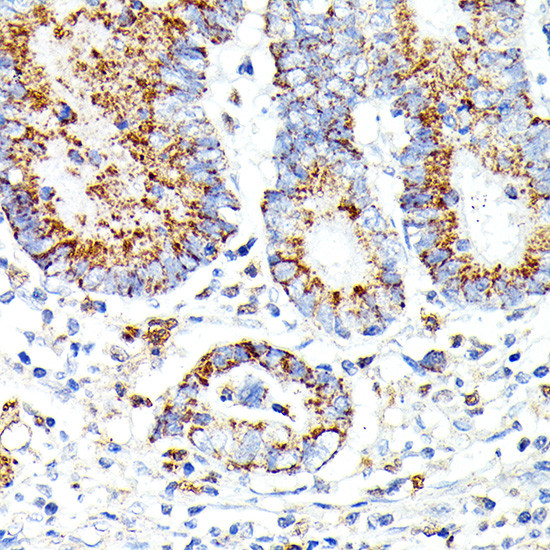
IL13RA2 Antibody in Immunohistochemistry (Paraffin) (IHC (P))

Search
Invitrogen
IL13RA2 Polyclonal Antibody
{{$productOrderCtrl.translations['antibody.pdp.commerceCard.promotion.promotions']}}
{{$productOrderCtrl.translations['antibody.pdp.commerceCard.promotion.viewpromo']}}
{{$productOrderCtrl.translations['antibody.pdp.commerceCard.promotion.promocode']}}: {{promo.promoCode}} {{promo.promoTitle}} {{promo.promoDescription}}. {{$productOrderCtrl.translations['antibody.pdp.commerceCard.promotion.learnmore']}}
图: 1 / 6
IL13RA2 Antibody (PA5-96045) in IHC (P)

Please note: We are reviewing Western blot images included in the antibody testing data in our catalog, including those provided by third parties. Unless expressly labeled or annotated as “raw-unedited”, Western blot images included in the antibody testing data in our catalog may have been edited, optimized or otherwise adjusted for presentation.
产品信息
PA5-96045
种属反应
宿主/亚型
分类
类型
抗原
偶联物
形式
浓度
规格
纯化类型
保存液
内含物
保存条件
运输条件
RRID
产品详细信息
Immunogen sequence: DTEIKVNPPQ DFEIVDPGYL GYLYLQWQPP LSLDHFKECT VEYELKYRNI GSETWKTIIT KNLHYKDGFD LNKGIEAKIH TLLPWQCTNG SEVQSSWAET TYWISPQGIP ETKVQDMDCV YYNWQYLLCS WKPGIGVLLD TNYNLFYWYE GLDHALQCVD YIKADGQNIG CRFPYLEASD YKDFYICVNG SSENKPIRSS YFTFQLQNIV KPLPPVYLTF TRESSCEIKL KWSIPLGPIP ARCFDYEIEI REDDTTLVTA TVENETYTLK TTNETRQLCF VVRSKVNIYC SDDGIWSEWS DKQCWEGEDL SKKTLLR; Positive Samples: THP-1, Mouse spleen, Rat thymus, Rat spleen; Cellular Location: Membrane, Single-pass type I membrane protein
靶标信息
IL13RA2 (interleukin-13 receptor subunit alpha-2) is closely related to IL13RA1, a subuint of the interleukin 13 receptor complex. This protein binds as a monomer to IL13 with high affinity, but lacks cytoplasmic domain, and does not appear to function as a signal mediator.
仅用于科研。不用于诊断过程。未经明确授权不得转售。
篇参考文献 (0)
生物信息学
蛋白别名: cancer/testis antigen 19; CD213a2; IL-13 receptor subunit alpha-2; IL-13R subunit alpha-2; IL-13R-alpha-2; IL-13RA2; interleukin 13 binding protein; interleukin 13 receptor alpha 2 chain; interleukin 13 receptor, alpha 2; Interleukin-13 receptor subunit alpha-2; Interleukin-13-binding protein; unnamed protein product
基因别名: CD213A2; CT19; IL-13R; IL-13R-alpha-2; IL13BP; IL13R; IL13RA2
UniProt ID: (Mouse) O88786
Entrez Gene ID: (Human) 3598, (Mouse) 16165, (Rat) 171060